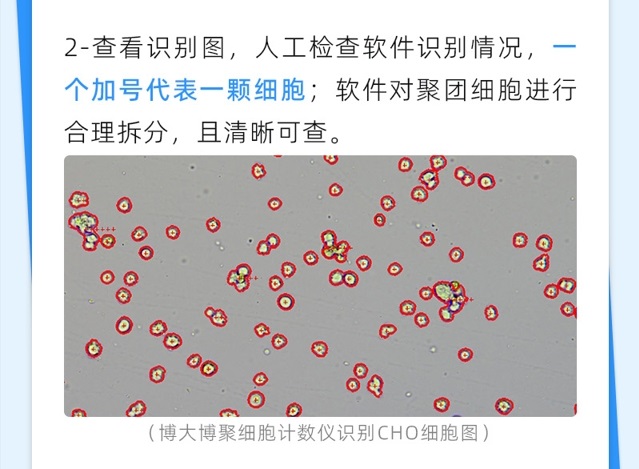

јҡ°ыУӢ”өғxК№УГјјЗЙЦ®ИзәОЕР”аУӢ”өҪY№ыөДңКҙ_РФ

- ЙъОпЦЖЛҺ4.0 ЈәЙПУО№ӨЛҮЦРПИЯMөДЯ^іМ·ЦОцјјРgЈЁPATЈ©
- LUNA-III™ЧФ„Ујҡ°ыУӢ”өғxөДРФДЬФu№А
- LUNA-III™јҡ°ыУӢ”өғxФЪЕ_ЕОЛ{ИҫЙ«PBMC»оБҰ·ЦОцЦРөД‘ӘУГ
- QUANTOM Tx™ОўЙъОпјҡ°ыУӢ”өғxФЪҝмЛЩҫъИә¶ЁБҝ·ЦОцСРҫҝЦРөД‘ӘУГғһ„Э
- QUANTOM Tx™ОўЙъОпјҡ°ыУӢ”өғxЦъБҰҸНлsОўЙъОпИәВд„У‘BЧғ»ҜСРҫҝ
- НЁЯ^LUNA-FX7™ЧФ„УҫЫҪ№Лг·ЁМбЙэөНқв¶Ијҡ°ыУӢ”өөДҫ«ҙ_РФ
- CytScop®ПөБРЦЗДЬјҡ°ыУӢ”өғxөДәЛРДјјРg„“РВј°GMP·ЁТҺПВөД‘ӘУГҲцҫ°
- јҡ°ыУӢ”өғxФЪҶОјҡ°ыңyРтЦРЯMРРңКҙ_УӢ”өәНҳУЖ·Щ|БҝтһЧCөД‘ӘУГғһ„Э
- ҝЈХжҫ«ІКББПаөЪ¶юҢГADC&РВРНҝ№уwЛҺОп№ӨЛҮ·е•ю
- ҝЈХжСыДъ№Іё°ADC&РВРНҝ№уwЛҺОп№ӨЛҮЩ|ҝШ·е•ю
- ьcіЙЦұІҘСыХҲЈәјҡ°ыУӢ”өөДҳЛңК»ҜЕcЦШҸНРФМбЙэІЯВФ
- 10ұ¶МбЙэУӢ”өР§ВК!ҝьҝЛМ©јҡ°ыУӢ”ө°еҙЩдN»о„Уй_КјАІ
- IGCөЪК®ҢГјҡ°ыј°СЬЙъОпСР°lЕc®aҳI»Ҝҙу•юИ«ЧhіМҪТД»
- ҝЈХжЙъГьҝЖҢWХ\СыДъ…ўјУ2025өЪК®ҫЕҢГјҡ°ы®aҳIҙу•ю
- °¬ШҗМ©СыДъЙкХҲFL2000јҡ°ыУӢ”өғxөДdemoФҮУГ
- ҝЈХжЙъГьҝЖҢWЦЗДЬјҡ°ыУӢ”өғxЦъБҰҢҚтһКТЦЗДЬ»ҜЙэјү
Copyright(C) 1998-2025 ЙъОпЖчІДҫW лҠФ’Јә021-64166852;13621656896 E-mailЈәinfo@bio-equip.com






